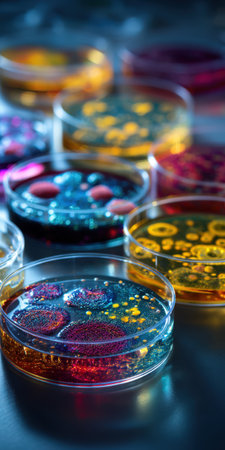
Petri dishes displaying various colored colonies of microorganisms and bacteria culturing on agar plates, representing microbiology research and scientific innovation in a laboratory settingの素材

素材 - Petri dishes displaying various colored colonies of microorganisms and bacteria culturing on agar plates, representing microbiology research and scientific innovation in a laboratory setting
作品情報
Petri dishes displaying various colored colonies of microorganisms and bacteria culturing on agar plates, representing microbiology research and scientific innovation in a laboratory setting
- ID:256928929
- 作品種別:
- 作者名:Olga Khelmitskaya
キーワード
- abstract
- agar
- analysis
- bacteria
- biology
- biotechnology
- chemistry
- colonies
- culture
- development
- diagnostics
- discovery
- disease
- experiment
- growth
- healthcare
- infection
- innovation
- investigation
- lab equipment
- laboratory
- medical
- medicine
- microbiology
- microscopic
- organism
- pathology
- petri dish
- pharmaceuticals
- research
- sample
- science
- scientific illustration
- scientist
- studying
- technology
- testing
- vaccine
- vertical
- virus
類似作品
stacks of color...
Dirty sink with...
Rustic wooden s...
lots of dirty w...
Close-up of sta...
A kitchen count...
Stack of white ...
Rows of empty p...
Wooden crockery...
Collage of diff...
Dirty dishes an...
Lots of dirty d...
drying dishes w...
Plates layer on...
shiny restauran...
Ceramic plates ...
white plates an...
lots of dirty w...
Chaos Unleashed...
Stack of colour...
Pile of clean p...
White storage s...
Stack of white ...
Many colorful c...
Clay plates for...
Clean dishes in...
Kitchenware and...
Rustic kitchen ...
Set of Festive ...
High cuisine. M...
Coffee cups arr...
Pottery plate a...
light ceramic c...
A chef standing...
?eramic bowls o...
Ceramic pottery...
Messy table aft...
porcelain plate...
Big set of empt...
Bowls were stac...
Fresh homemade ...
Pile Of Plates ...
Variety of fres...
All set and rea...
Dirty dish with...
A vibrant colle...
Empty plate
Lots of dirty d...